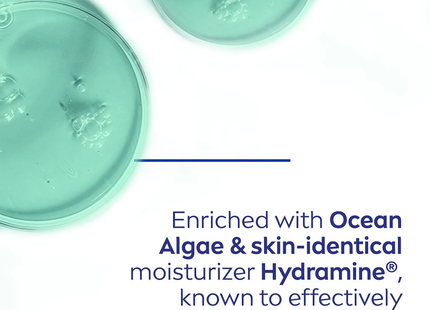
Nivea - Purifying Toner with Ocean Algae for Combination to Oily Skin | 200 mL

Nivea - Purifying Toner with Ocean Algae for Combination to Oily Skin | 200 mL
- BrandNivea
Free pickup in store
SKU: 05659400470
$10.39 $9.49
%3Cp%3EEarn%20[points_amount]%20when%20you%20buy%20this%20item.%3C/p%3E
Free shipping on orders over $85 before tax. Some conditions apply, see Important Info tab on the Shipping & Returns page for more information.
Features
-
Guaranteed secure & safe checkout.